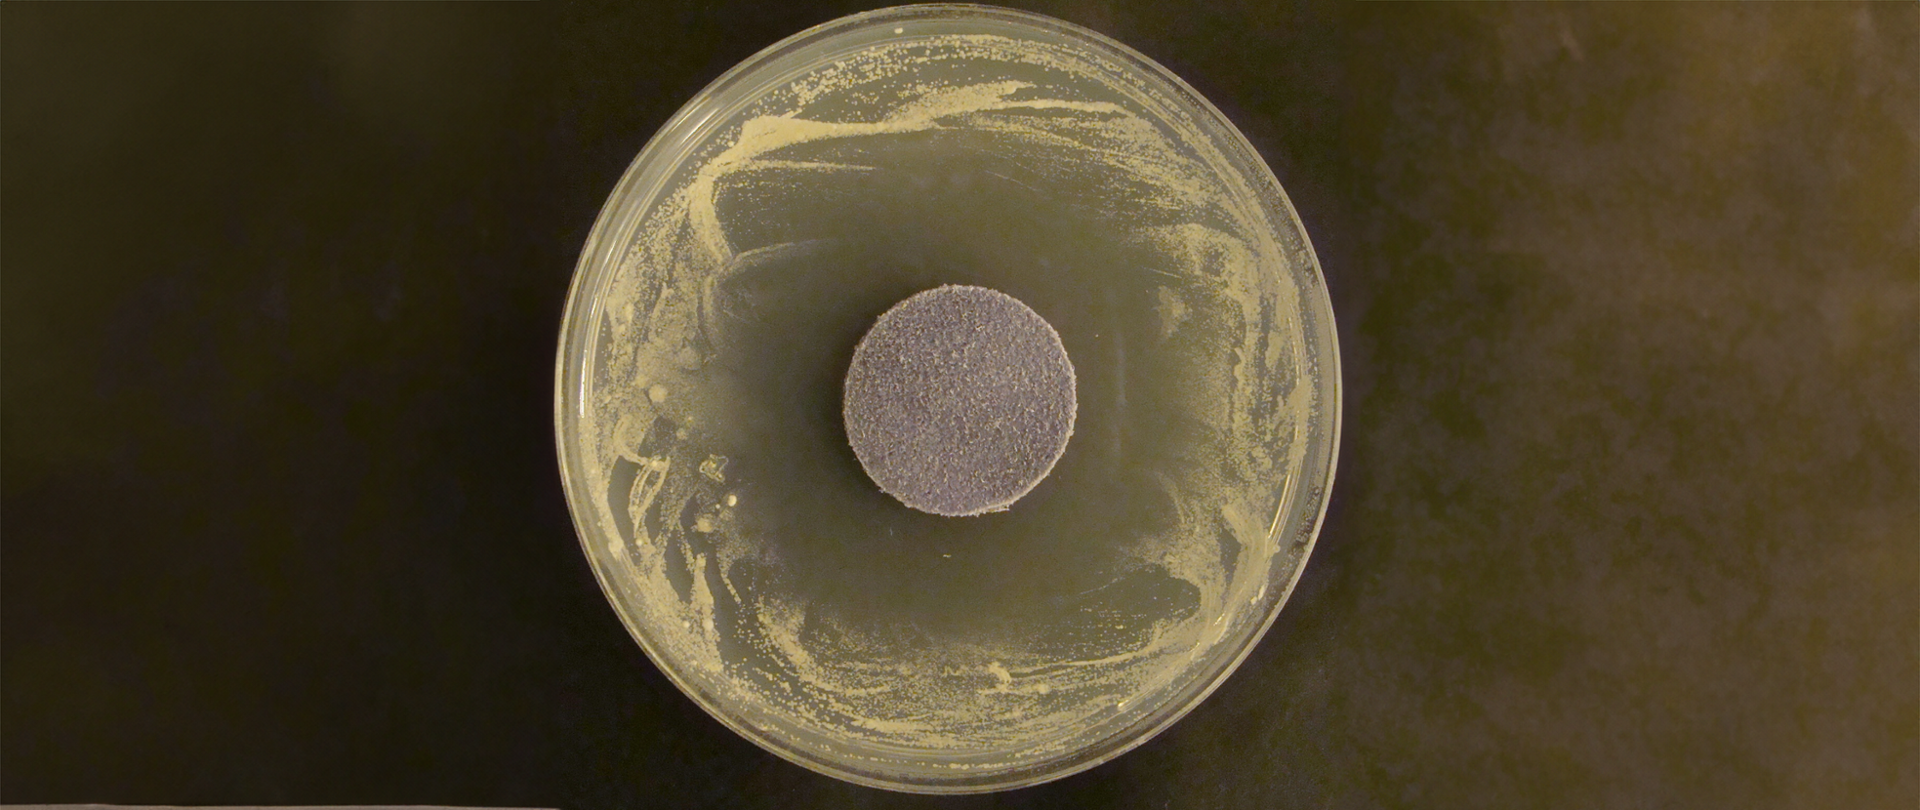
Zdjęcie 2

Opracowanie mikrobiologiczne aktywnych, przyjaznych dla użytkownika i środowiska materiałów dla przemysłu lekkiego
Tytuł projektu
Tytuł projektu
Opracowanie mikrobiologiczne aktywnych, przyjaznych dla użytkownika i środowiska materiałów dla przemysłu lekkiego
 Nazwa Beneficjenta/Beneficjentów
Nazwa Beneficjenta/Beneficjentów
Stowarzyszenie Włókienników Polskich, Uniwersytet Ekonomiczny w Krakowie, Łukasiewicz Łódzki Instytut Technologiczny
 Nazwa programu
Nazwa programu
Programy międzynarodowe
 Konkurs
Konkurs
Inicjatywa CORNET – 28. Konkurs
 Wartość projektu
Wartość projektu
1 798 333,00 PLN
 Wartość dofinansowania
Wartość dofinansowania
1 765 895,00 PLN
 Okres realizacji projektu
Okres realizacji projektu
od 1.09.2020 r. do 01.11.2022 r.
Zobacz efekt naszej pracy
Zdjęcie 1 Aktywność bydlęcej skóry podszewkowej uszlachetnionej olejkiem miętowym wobec drożdży Candida albicans (kąpielowa metoda aplikacji olejku do skóry w stanie wet-blue)
Zdjęcie 2 Aktywność bydlęcej skóry podszewkowej uszlachetnionej olejkiem cynamonowym wobec pleśni Scopulariopsis brevicaulis (natryskowa metoda aplikacji olejku do skóry w stanie crust)
Zdjęcie 3 Aktywność dzianiny bawełnianej uszlachetnionej olejkiem z oregano wobec bakterii Staphylococcus aureus (natryskowa metoda aplikacji olejku)
Jaki problem rozwiązuje nasz projekt?
W wyniku realizacji projektu AroLeather opracowane zostały innowacyjne materiały – skóry i materiały tekstylne – które dzięki modyfikacji roślinnymi olejkami eterycznymi charakteryzują się aktywnością przeciwdrobnoustrojową oraz atrakcyjnym zapachem. Odpowiednia czystość mikrobiologiczna i higiena obuwia, która może zostać uzyskana dzięki zastosowaniu opracowanych, wykazujących działanie antymikrobowe materiałów, jest szczególnie istotna dla osób zmagających się z infekcjami grzybiczymi w obrębie skóry stóp i paznokci, ale także dla osób zdrowych, prowadzących aktywny tryb życia. Wykorzystanie skór i/lub materiałów tekstylnych wzbogaconych naturalnymi substancjami o działaniu przeciwdrobnoustrojowym wpłynie znacząco nie tylko na poprawę komfortu użytkowego, ale i na trwałość wyrobu. Będzie to możliwe dzięki ograniczaniu wzrostu i rozwoju mikroorganizmów przyśpieszających degradację materiałów wnętrza obuwia. Zaproponowana w ramach projektu technologia wykończania skór z wykorzystaniem olejków eterycznych stanowi także istotne rozwiązanie dla przemysłu garbarskiego. Zastosowanie tych naturalnych, ekologicznych antyseptyków stwarza możliwość wyeliminowania z procesu produkcji skór, bądź znacznego ograniczenia użycia, wykazujących różny poziom toksyczności biocydów syntetycznych.
Kto skorzysta z wyników projektu?
Z wyników projektu skorzystają przedsiębiorcy z branży MŚP, którzy będą mieli możliwość wdrożenia opracowanego produktu, atrakcyjnego dla użytkownika końcowego. Wzbogacenie oferty o nowy, innowacyjny produkt pozwoli na wzmocnienie ich pozycji rynkowej. Dodatkowo zastosowanie ekologicznych materiałów, uszlachetnionych naturalnymi olejkami eterycznymi poprawi wizerunek branży, a także zwiększy potencjał techniczny przedsiębiorstw.
Wyniki projektu mogą również stanowić punkt odniesienia do opracowania i wdrożenia technologii produkcji materiałów mikrobiologicznie aktywnych w warunkach przemysłowych, np. w garbarniach.


